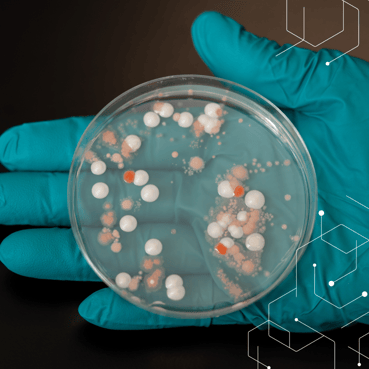
BLOG IMAGE SQUARE (3)

USP <797> FAQs: Positive and Negative Controls
- By: Rhonda Lintner, MPH, B.S.
- Tags: USP 797
At its essence, USP <797> is a quality control (QC) standard used to protect patients from contamination that can occur when pharmacies produce compounded sterile preparations (CSPs). Media-fill, gloved fingertip, surface sampling, and other tests are used to confirm personnel competency and ensure bioburden control of compounding areas and personnel. For these results to be valid, the medium used in these tests must be uncontaminated and capable of supporting growth. This can be confirmed using positive and negative controls.
We touched on controls in our last webinar and a recent blog. In this post, I will go deeper into the topic, answering some of the questions and concerns we get from clients when we discuss the need for positive and negative controls.
What are Positive and Negative Controls?
The use of positive and negative controls isn’t explicitly covered in USP <797>. However, they are an essential element in other quality control standards, so many compounding pharmacies will already be familiar with the concept. To set the stage for the rest of our discussion, here is the simple definition of each term:
Positive controls are media devices that are intentionally inoculated at the laboratory with a known microorganism to ensure the media can support microbial growth if any organisms are present.
Negative controls, on the other hand, are media devices that are not inoculated with any microorganisms, and therefore, should yield no growth if the medium was kept under proper conditions, per the manufacturer’s Instructions for Use (IFU). Growth may indicate the device was damaged/breached during transport or handling.
SOPs for Failed Control Tests
In addition to defining when positive and negative control tests should be run, your SOPs should delineate the steps taken in the event of a failed control test. There is no defined process in USP <797>, but building on our laboratory experience and knowledge of other quality standards, we can offer high-level guidelines to consider.
No growth on positive controls may indicate that the media was stored inappropriately and, therefore, cannot support microbial growth. In this instance, additional testing can help determine whether the entire media lot is impacted or if the problem is limited to a specific media device. Environmental monitoring should always be repeated if the media cannot support growth.
Growth on negative controls is more common than no growth on positive controls. Handling of devices during storage or shipping can lead to contamination. Condensation on the rim of plates is particularly common. Water can provide a “bridge” to enable microorganisms to enter an agar plate despite lock-lid technology and tape or parafilm. If surface or air samples show a similar pattern of growth on the rim, the observed growth can potentially be interpreted as contamination during handling versus contamination of the sampling site.
Observable growth on a negative control should never be used to justify dismissing positive findings in surface and air samples. However, it can support root-cause investigations and help QC personnel find and address potential flaws in the process.
Growth Promotion Tests
Lastly, it’s important to distinguish between controls run by media device manufacturers and those run at the laboratory. Device manufacturers perform growth promotion tests on their products before shipment as part of their QC program. The results of these tests, including the organisms used for each growth medium, are required to be listed on the Certificate of Analysis (COA) for each lot number.
The COA should also include the results of the vendor’s visual inspection of the device. This includes aspects such as appearance (e.g., color, clarity, no visible damage), consistency, fill level, and pH. High-quality media device manufacturers will include additional information regarding their QC practices on every COA as well.
USP <797> revisions require good documentation practices, which include immediately retrieving the COA from the manufacturer’s website upon receiving each order and saving that COA for your records. However, even with a COA on file, it is imperative to check all media for physical damage (e.g. condensation, dried growth media, cracks, etc.) upon receipt and again before use.
Never use media devices that look “off” or are physically damaged in any way. Furthermore, the vendor’s growth promotion tests do not replace the positive and negative control tests performed by your laboratory partner.
Our Stance on Positive and Negative Controls
As noted, USP <797> doesn’t require positive and negative controls. In fact, the standard doesn’t even mention them, although other quality control standards do. Nevertheless, as I’ve cautioned many times before, USP <797> is a standard of minimums. Each compounding pharmacy needs to determine whether positive and negative controls should be used based on their risk assessment.
For our part, we always recommend using both positive and negative controls for every lot. Furthermore, do not forget that positive and negative controls should also be run on your media-fill products, such as media-fill bags and bottles. However, we do not require these tests and will only run them if requested by the client. If you have questions about using controls – or anything else having to do with USP <797> compliance – I encourage you to reach out to us.